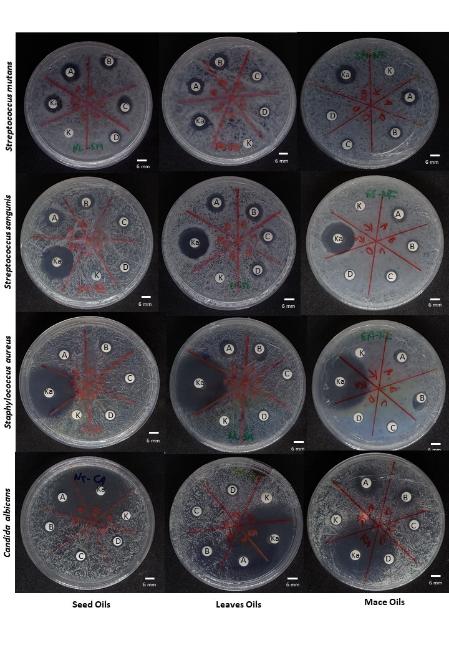

Trends
Sci.
2026;
23(4):
11609
Bioactivities of Nutmeg Essential Oils: Their Effect on Growth and Abnormality of Oral Cavity Microbes
Renny Utami Somantri1,4, Sugiarto2, Khaswar Syamsu2,
Titi Candra Sunarti2,*, Evi Savitri Iriani3 and Syahri4
1Agroindustrial Technology Study Program, Graduate School of IPB University, Bogor 16680, Indonesia
2Department of Agroindustrial Technology, Faculty of Agriculture Technology, IPB University, Bogor 16680, Indonesia
3Agency for Agricultural Assemblies and Modernization, Jakarta 12540, Indonesia
4ROAF, National Research and Innovation Agency, Cibinong 16911, Indonesia
(*Corresponding author’s e-mail: [email protected])
Received: 15 August 2025, Revised: 10 September 2025, Accepted: 10 October 2025, Published: 25 December 2025
Abstract
Nutmeg essential oils (EOs) possess significant antibacterial and antifungal activities. This study evaluated the effects of EOs from nutmeg leaves (LEO), seed (SEO), and mace (MEO) on the growth of microorganisms. The aim of the study was to evaluate nutmeg essential oils ability to inhibit microbial growth and alter cell structures. Each EO was tested at 4 concentrations (500, 250, 150 and 77 mg/mL) against 3 Gram-positive bacteria - Staphylococcus aureus, Streptococcus mutans, and Streptococcus sanguinis - and the opportunistic fungus Candida albicans. Antimicrobial activity was assessed through growth inhibition assays, minimum inhibitory concentration (MIC), and growth rate analysis. Scanning electron microscopy (SEM) was used to observe cell morphology changes, while GC-MS analysis identified chemical composition. β-pinene, sabinene, D-limonene, terpinen-4-ol and myristicin were major components in nutmeg oil. All EOs inhibited microbial growth and prevented progression into the logarithmic phase. MIC varied between 75 and 300 mg/mL. Minimum inhibitory concentrations for bacteria were in the range of 150 - 300 mg/mL, while that for fungi were 75 - 150 mg/mL. Minimum bactericidal concentration (MBC) were 300 to 600 mg/mL and minimum fungicidal concentrations (MFC) was 150 mg/mL. Overall nutmeg EOs exhibited moderate activity, producing inhibition zones greater than 8 mm. Microbial counts declined within 4 h of exposure and continued decreasing over 24 h. SEM revealed cell lysis, surface wrinkling, and disrupted cell aggregates. These findings indicate that nutmeg EOs induce cell death and inhibit rapid microbial proliferation through cell lysis, supporting their potential as safe, plant-based alternatives for oral infection management.
Keywords: Nutmeg, Essential oil, Antibacterial activity, Antifungal activity, Botanicals
Introduction
The human oral cavity hosts a diverse microbiota comprising over 700 species of fungi, bacteria, and viruses, including opportunistic pathogens, forming a diverse and dynamic microbial ecosystem [1,2]. This diversity facilitates the development of polymicrobial infections, such as those involved in dental caries formation [2]. Streptococcus mutans and Streptococcus sanguinis are significant groups of cariogenic bacteria [3]. Oral bacteria, particularly Streptococcus mutans, Streptococcus sanguinis, and Porphyromonas gingivalis play a central role in systemic inflammation that can lead to life-threatening conditions. These bacteria can enter the bloodstream from inflamed gums, triggering cytokine release and platelet activation, which promote atherosclerosis, thrombosis, hypertension, arrhythmias, and coronary artery disease, ultimately increasing the risk of heart attack, stroke, and death [4,5]. Furthermore, Koren et al. [6] demonstrated that bacteria from the oral cavity and gut, including Streptococcus and Veillonella, are present in atherosclerotic plaques, and that the abundance of specific microbes correlates with plasma lipid levels. This evidence highlights a mechanistic link in which oral and gut dysbiosis worsen metabolic and immunologic disorders, thereby increasing the risk of hypertension, coronary artery disease, and other fatal conditions [6]. Candida albicans and S. mutans interact synergistically to form highly virulent biofilms related to early childhood caries [7]. While Staphylococcus aureus is a member of the normal oral flora, it can cause oral infections under predisposing conditions [8]. Moreover, human candidiasis, affecting oral and other mucosal surfaces, is often caused by opportunistic yeast infections from C. albicans [9]. Oral microbiota composition varies widely, and maintaining microbial balance is essential for preventing oral diseases. Recently, green medicine has gained global attention, with increasing demand for plant-based pharmaceuticals, as they provide various bioactive compounds with fewer side effects [10].
Nutmeg (Myristica fragrans Houtt.), a dioecious evergreen spice native to Indonesia and a member of the Myristicaceae family, originates from the Banda Islands, also known as the Spice Islands, and is well recognized for its antimicrobial properties [11,12]. Various parts of the plant, including seeds, mace, pericarp, and pulp, have long been used in traditional Chinese, Thai, and Ayurvedic medicine. Extracts from its root, seed, fruit, and bark have demonstrated antimicrobial, antithrombotic, psychostimulant, and antioxidant activities [12-14]. Recent studies also highlight its potential as a natural source of bioactive compounds for food preservation and pharmaceutical applications [15].
Nutmeg essential oil contains a range of volatile compounds with promising antimicrobial properties, such as myristicin, sabinene, α-pinene, elemicin, eugenol, and linalool [11,16]. Myristicin, one of nutmeg essential oil marker compounds exhibits strong antibacterial activity, effective against pathogens like S. aureus and S. pneumoniae, highlighting its potential for novel antimicrobial therapies [15]. Recent studies have reported that nutmeg extracts and essential oil exhibit inhibitory activity against various pathogens, including Streptococcus mutans, Streptococcus sanguinis, Candida albicans, and Staphylococcus aureus, which are implicated in dental caries and other oral infections [11,17-19]. Numerous researchers have examined the antimicrobial properties of nutmeg [10-19]. Despite these promising findings, there is limited comprehensive research comparing antimicrobial activities essential oils extracted from different nutmeg parts, such as seeds, leaves, and mace, specifically against oral cavity microorganisms. Therefore, evaluating their ability to inhibit microbial growth and alter cell structures remains an important step in developing natural oral care formulations.
Materials and methods
Microbial culture preparation
Three Gram-positive bacteria (S. sanguinis ATCC 10558, S. mutans, S. aureus ATCC 6538) and a strain of opportunistic fungi (C. albicans ATCC 10231) used in this research are collected from the IPB University Culture Collection (IPB-CC). The microbial strains from the stock were transferred to Nutrient Broth (NB) agar (Himedia, Mumbai, India) and incubated overnight at 37 °C. The microbial suspensions were prepared in NB media and incubated for 24 h with the cell population around 109 cfu/mL.
Nutmeg oils preparation
This study assessed 3 essential oils extracted from different nutmeg parts (seeds, leaves, and mace), that are commercially obtained from Pavettia Essential Oils (Indonesia). Based on the certificate, nutmeg EOs were extracted by steam distillation of nutmeg seed, leaves, and mace. The determination of phytochemicals in oil using gas chromatography, conducted following Ramli et. al [20] with modification. The instrument used Agilent Technologies 7890 Gas Chromatograph with AutoSampler and 5975 Mass Selective Detector. The system equipped with HP INNOWAX capillary column (30 m×0.25 mm, 0.25 μm). For detection, an electron ionization system with 70 eV ionization energy was used. The carrier gas was helium at a flow rate of 0.6 mL/min. The injector, ion source, and interface temperature were set to 250, 230, and 280 °C, respectively. The column temperature was initially kept at 60 °C for 0 min, then increased at a ramp rate of 2 °C/min to 150 °C, held for 1 min, and finally raised at 20 °C/min to 210 °C.
Determination Minimum Inhibition Concentration (MIC)
The screening of the nutmeg oils and their MIC were determined using the microdilution technique in 96-well microplates sterile (U-bottom). To each well of a plate, 50 μL of NB (Himmedia, India) was added except for the wells in the first column, which were filled with 60 μL of nutmeg oil, 10 μL of DMSO, and 30 μL of NB to obtain an initial concentration of 60%. DMSO was used only in the first column, where it acted as a co-solvent/surfactant to homogenize oil with liquid media. Serial 2-fold dilutions were then performed by transferring 50 μL aliquots from one column to the next, resulting in final concentrations of 60%, 30%, 15%, 7.5%, and so on, which were used for MIC determination. After adding 10 μL of test microbes to each well, each plate column contained a specific strain. The same assay settings were used to control microbial strain viability in liquid media. Seal the plates and incubate at 30 ± 2 °C for 24 h. Following incubation, 10 μL of resazurin was added to each well and diluted for 4 h. After adding resazurin, the concentration on the plate that did not change color was used to calculate the MIC.
Evaluation effects of nutmeg oils on oral cavity microbes in vitro
The study was arranged in a completely randomized design with 6 treatments and repeated in 3 replications. The paper disc diffusion test measured the ability of nutmeg oils to inhibit oral cavity microbes. Nutmeg oil was diluted with dimethyl sulfoxide (DMSO) before application. Each oil will be evaluated for its efficacy against oral cavity microorganisms using a treatment consisting of (A) 500 mg/mL nutmeg oil, (B) 250 mg/mL nutmeg oil, (C) 150 mg/mL nutmeg oil, (D) 77 mg/mL nutmeg oil, (E) positive control, and (F) negative control (DMSO). As a positive control, 100 ppm penicillin was used against S. aureus, S. mutans, and S. sanguinis, in contrast, 150 ppm conazole was applied on C. albicans [21]. About 100 uL (109 cfu/mL) of 24-hour-old microorganisms from NB culture were evenly spread on Petri dishes ( = 9 cm) containing NB agar. On the surface of the medium, 10 µL of nutmeg oil and control was poured onto 6 pieces of sterile disc paper ( = 6 mm). The cultures of S. sangunis, S. mutans, and S. aureus were incubated for 24 h, while C. albicans were incubated for 48 h. The clear zone around the disc paper was measured using a digital caliper in 3 replicates. Based on inhibition zone diameter (IZD) data, antimicrobial susceptibility threshold limits were set: IZD ≥ 11 mm: Sensitive; 8 - 11 mm: moderate; IZD < 8 mm: Resistant.
Determination of the effect of EOs on the growth rate of oral cavity microbes
The effect of EOs on microbe growth was measured by inoculating 100 µL of the microbe suspension (109 cfu/mL) to 30 mL NB media. After that, 6 mL of the nutmeg oil was added to the solution at a concentration of 100 mg/mL and then shaken for 30 s. The cultures were incubated statically at ambient temperature for 24 h. The mixture’s absorbance at 600 nm was used to measure nutmeg oil’s microbial growth inhibition. The absorbance was measured at intervals of 2, 4, 6, 8, 12, 16, 20 and 24 h of incubation.
Detection of change on cells morphology and architecture of microbes
Scanning electron microscopy (SEM) was used to visualize oral cavity microbe cell morphology. Nutmeg oil was dissolved in DMSO to a concentration of 10 mg/mL, then added to 10 mL test tubes containing oral cavity microbes (109 cfu/mL). An inoculated growth medium without the nutmeg oil was used as a control. The cultures were exposed in 8 h based on the initial period of population decline peak. Cell structural alterations were seen by SEM (JSM-IT200, JEOL, Tokyo, Japan). Before the SEM, the culture was centrifuged for 10 min at 6,000 rpm and a temperature of 4 °C. A 2.5% glutaraldehyde solution was added to the pellets with volume 4:1. The sample was cleaned in a cacodylate buffer for 2 h and ultrasonically for 5 min. The sample was soaked in 2.5% glutaraldehyde for several h. It was fixed in 2% tannic acid for 6 h and washed 4 times in cacodylate buffer for 5 min. Every procedure was conducted at a temperature of 4 °C. The ethanol dehydration series was performed at room temperature: 4 immersions in 50% alcohol for 5 min, 70% alcohol for 20 min, 85% alcohol for 20 min, 95% alcohol for 20 min, and 10 min of absolute alcohol immersion twice. The final step is dehydrating, preceded by 2 10-minute immersions in a tert-butanol solution. The samples were frozen and freeze-dried. Before SEM examination, desiccated specimens were fixed to stubs and coated with Au using an ion coater. The samples were SEM-viewed at 10,000× magnification.
Results and discussion
Phytochemical component of nutmeg oils
Table 1 summarizes the GC-MS profiling of bioactive constituents in nutmeg (Myristica fragrans) leaf, seed, and mace essential oils. The analysis revealed alpha-pinene, beta-pinene, sabinene, myristicin, and D-limonene were identified as major compounds in nutmeg leaf, seed, and mace essential oils. Nutmeg leaf oil contained mostly beta-pinene (35.06%), sabinene (13.59%), D-limonene (7.61%), myristicin (7.06%), beta-myrcene (4.74%), and o-cymene (4.04%).
Table 1 Phytochemical compounds of nutmeg leaf, seed, and mace essential oil.
Phytochemical compound |
Leaf |
Seed |
Mace |
|||
RT |
Con. (%) |
RT |
Con. (%) |
RT |
Con. (%) |
|
α-pinene |
|
|
|
|
3.357 |
16.50 |
Camphene |
3.599 |
1.00 |
3.572 |
1.06 |
3.943 |
0.24 |
α-fenchene |
|
|
|
- |
3.818 |
0.01 |
β-pinene |
4.244 |
35.06 |
4.217 |
14.42 |
4.633 |
12.53 |
Sabinene |
4.432 |
13.59 |
4.432 |
11.86 |
4.877 |
16.73 |
trans-Sabinene hydrate |
|
|
|
|
21.579 |
1.07 |
α-terpinolen |
|
|
|
|
9.375 |
2.76 |
linalool |
|
|
|
|
21.922 |
0.26 |
(+)-3-Carene |
4.969 |
5,63 |
4.969 |
9.99 |
5.442 |
2.58 |
beta-Myrcene |
5.2655 |
4.74 |
|
|
5.764 |
1.61 |
α-phellandrene |
|
|
5.291 |
4.55 |
5.821 |
1.31 |
1,3-Cyclohexadiene, 1-methyl-4-(1-methylethyl) |
5.641 |
1.22 |
5.641 |
8.05 |
|
|
(+)-4-carene |
|
|
|
|
6.179 |
2.25 |
D-limonene |
6.098 |
7.61 |
6.098 |
6.84 |
6.683 |
4.04 |
β-phellandrene |
6.339 |
3.72 |
6.339 |
4.62 |
6.947 |
2.48 |
-terpinene |
7.441 |
1.35 |
7.441 |
2.88 |
8.099 |
3.46 |
O-Cymene |
8.247 |
4.04 |
8.247 |
4.63 |
|
|
Cyclohexene. 1-methyl-4-(1-methylethylidene) |
8.650 |
1.65 |
8.650 |
1.99 |
|
|
β-Cymene |
|
|
|
|
8.950 |
0.49 |
β-Terpineol |
|
|
|
|
17.345 |
1.38 |
Copaene |
17.410 |
1.06 |
|
|
|
|
Linalool |
21.145 |
2.05 |
|
|
21.922 |
0.26 |
Terpinen-4-ol |
23.536 |
3.38 |
23.536 |
3.08 |
24.391 |
5.10 |
Hexylene glycol |
|
|
25.364 |
1.17 |
|
|
α-terpineol |
|
|
28.695 |
0.66 |
29.492 |
0.65 |
Safrole |
37.670 |
1.37 |
|
|
38.401 |
4.57 |
Methyl eugenol |
|
|
|
|
45.696 |
0.24 |
Eugenol |
48.956 |
1.25 |
|
|
49.037 |
0.99 |
Myristicin |
50.192 |
7.06 |
50.192 |
10.49 |
50.293 |
16.53 |
Isoeugenol |
|
|
|
|
51.466 |
0.86 |
Methoxyeugenol |
|
|
|
|
54.812 |
0.27 |
RT = retention time; Conc. = percentage of substance.
Nutmeg seed oil was predominantly composed of beta-pinene (14.42%), sabinene (11.86%), myristicin (10.49%), D-limonene (6.84%), also alpha-phellandrene, beta- phellandrene, and o-cymene each at 4%. Nutmeg mace oil major compounds were sabinene (16.73%), alpha-pinene (16.50%), beta-pinene (12.53%), myristicin (16.53%), terpinen-4-ol (5.10%), and safrole (4.57%). Other reported primary components in nutmeg seed oil extracted in Romania are sabinene (21.71%), alpha-pinene (15.81%), myristicin (13.39%), and beta-pinene (12.70%) [22]. While anothers have detected beta-phellandrene (27.80%), alpha-pinene (15.35%), beta-pinene (8.22%), and o-cymene (7.42%) from nutmeg seed oil in Malaysia [20]. Seed oil extracted in Serbia contained sabinene (42.6%), methyl eugenol (8%), and beta-pinene, limonene, terpinen-4-ol each at approximately 6% [19]. Mace essential oil extracted in Pakistan were rich in safrole (49.09%), beta-phellandrene (18.27%) and 3-p-Menthene (10.76%) [12].
The result indicated that the major compounds in nutmeg essential oil were monoterpene hydrocarbons, which are known to disrupt microbial cell membrane and increase permeability, leading to leakage of cell contents in bacteria and fungi. Alpha-pinene and beta-pinene showed toxicity against membrane cell, moreover alpha-pinene also found to be antibiotic resistance modulator [11]. In contrast nutmeg mace oil contained notable amounts of monoterpene alcohols (linalool, terpinen-4-ol, beta-terpineol), which generally exhibit stronger antimicrobial effects than hydrocarbons because of the presence of hydroxyl group that improves solubility and penetration into microbial membranes. Additionally, nutmeg mace oil also contained phenolic phenilpropanoids (eugenol, isoeugenol, metoxyeugenol) that are bactericidal at low concentration and effective in inhibiting fungal growth. Eugenol was also detected in nutmeg leaf oil, is recognized as one of key contributors to both antibacterial and antioxidant activities. Previous study have reported eugenol effectiveness against methicillin-resistant Staphylococcus aureus (MRSA), and exerts its antimicrobial action through multiple mechanisms, including inhibition specific enzyme and toxin, interference with ion and ATP transport, suppression of biofilm formation, alternation of cell morphology, cytoplasmic membrane disruption and induction of intracellular ROS, and in fungi disrupting lipid layers and cell wall biosynthesis; it can also interfere with viral replication processes [15,23,24]. Myristicin, a major key constituent of nutmeg oil, is a phenylpropanoid. Table 1 revealed the essential oil from nutmeg mace contained the highest amount of myristicin compare to the oil from the leaves and the seed. Myristicin exhibits antibacterial effects by binding to bacterial lipid membranes, disrupting their structure, increasing permeability, and causing leakage of essential cellular components. It also interferes with ATP synthase and other metabolic enzymes, leading to impaired energy production and cell death, while showing selective toxicity toward bacteria over mammalian cells. Myristicin has demonstrated strong activity against pathogens such as MRSA, Staphylococcus aureus, and Streptococcus pneumoniae [15]. Other study reported myristicin in nutmeg exhibits anti-inflammatory activity by surpressing pro-inflammatory mediators, including cytokines, chemokines, and growth factors, in RNA-stimulated macrophages [25].
Minimum Inhibitory Concentration (MIC)
Nutmeg essential oil (EO) exhibited minimum inhibitory concentrations ranging from 75 to 300 mg/mL (Table 2). The MIC values were greatest against S. sanguinis (300 mg/mL) for all tested oils, suggesting that S. sanguinis was the least sensitive to nutmeg oil. Conversely, C. albicans exhibited the lowest MIC, with 75 mg/mL for seed and leaf oils and 150 mg/mL for mace oil, indicating greater susceptibility. Both S. aureus and S. mutans exhibited MIC values of approximately 150 mg/mL, indicating intermediate levels of susceptibility. Because C. albicans exhibits slower growth, the active components of nutmeg oil have a more pronounced effect before significant microbial replication occurs. In contrast, rapidly growing bacteria require higher concentrations of nutmeg oil to achieve effective inhibition.
Table 2 MIC and MBC/MFC of nutmeg oils against oral cavity microbes.
Microbe strains |
Nutmeg leaf oil |
Nutmeg seed oil |
Nutmeg mace oil |
|||
MIC (mg/mL) |
MBC/MFC (mg/mL) |
MIC (mg/mL) |
MBC/MFC (mg/mL) |
MIC (mg/mL) |
MBC/MFC (mg/mL) |
|
Streptococcus mutans |
150 |
300 |
150 |
300 |
300 |
300 |
Streptococcus sanguinis ATCC 10558 |
300 |
600 |
300 |
600 |
300 |
300 |
Staphylococcus aureus ATCC 6538 |
150 |
300 |
150 |
300 |
150 |
300 |
Candida albicans ATCC 10231 |
75 |
150 |
75 |
150 |
150 |
150 |
Similar patterns were observed for the antibacterial and antifungal activities of nutmeg essential oils (Table 2). C. albicans was susceptible to all nutmeg oils at approximately 150 mg/mL, whereas the bacterial strains required higher concentrations (300 - 600 mg/mL) to achieve bactericidal activity. Notably, the minimal bactericidal concentration (MBC) of nutmeg mace oil against all tested bacteria was 300 mg/mL. For seed and leaf oils, the MBC against S. mutans and S. aureus was also 300 mg/mL, while a higher concentration of 600 mg/mL was necessary to effectively kill S. sanguinis. These results indicate that higher concentrations of nutmeg oil are required to target S. sanguinis. Importantly, in polymicrobial infections, reducing the activity of one microbial species at a particular concentration may not be sufficient to inhibit other coexisting microorganisms. For instances S. mutans and C. albicans in dental plaque biofilms. These microorganisms appear to form a cross-kingdom symbiotic interaction that enhances the pathogenicity of S. mutans biofilm. S. mutans-C. albicans biofilm matured more rapidly and maintained a low pH (~4.3), whereas S. mutans biofilms developed more slowly and failed to create an acidic environment. Consequently, enamel surfaces were severely demineralized by S. mutans-C. albicans biofilms, while S. mutans biofilms caused minimal damage. It is highlighting the need for antimicrobial agents capable of targeting multiple microbes simultaneously [7].
The effect of nutmeg oils on growth of oral cavity microbes in vitro
The study demonstrated that nutmeg oil effectively inhibits the development of oral cavity microorganisms in vitro (Tables 3 - 6, Figure 1). Antimicrobial effects of nutmeg essential oil were previously documented against Gram-positive and Gram-negative bacteria, yeasts, and fungi [12,22]. Nutmeg seed spent extract showed potent activity against Gram-positive bacteria, however, it is no significant effects on Gram-negative bacteria or yeasts [22].
Table 3 Effect of nutmeg oil on the growth of Streptococcus sanguinis.
Treatments |
Diameter of inhibition zone (mm) by essential oils from- |
|
||
Seeds (x ± SD) |
Leaves (x ± SD) |
Mace (x ± SD) |
||
Positive control |
21.30 ± 2.47 |
20.96 ± 1.04 |
20.70 ± 0.44 |
|
EO 500 mg/mL |
11.25 ± 3.63ab |
12.59 ± 0.90a |
9.77 ± 2.64ab |
|
EO 250 mg/mL |
10.71 ± 0.92ab |
11.27 ± 0.71ab |
8.57 ± 0.45ab |
|
EO 150 mg/mL |
8.58 ± 0.96ab |
9.93 ± 2.54ab |
8.39 ± 0.41b |
|
EO 77 mg/mL |
8.26 ± 0.33b |
9.06 ± 0.54ab |
7.26 ± 0.33b |
|
Means ± SD (n = 3). Different letters within column/row indicate significant differences at p < 0.0.5 (Tukey’s HSD).
Table 3 showed that nutmeg essential oil effectively inhibited the growth of Streptococcus sanguinis. Among the 3 oil types, nutmeg leaf oil exhibited the strongest inhibitory effect, surpassing both mace and seed oils. Although there was no statistically significant difference in the inhibitory activity between mace and seed oils at the tested concentrations, varying the concentration of leaf oil had a notable impact on antimicrobial efficacy. At 77 mg/mL, all 3 oils inhibited pathogen growth, producing inhibition zones of 8.26 mm (leaf oil), 9.06 mm (mace oil), and 7.27 mm (seed oil). The greatest inhibition of S. sanguinis was observed with a 500 mg/mL concentration of leaf oil, yielding an inhibition zone of 12.59 mm, whereas the least effective inhibition occurred with 77 mg/mL of mace oil, showing an inhibition zone of only 7.26 mm. The superior antimicrobial activity of nutmeg leaf oil is likely attributed to its higher content of phenolic compounds, which are known to disrupt microbial cell membranes and interfere with cellular metabolism, thereby enhancing its effectiveness compared to seed oil.
Figure 1 Growth inhibition of oral cavity microbes by several types of nutmeg oils (A: 500 mg/mL, B = 250 mg/mL, C = 150 mg/mL, D = 77 mg/mL, K = positive control-antibiotic).
The effects of nutmeg essential oil on inhibiting the growth of Streptococcus mutans were found to be largely comparable across different oil types (Table 4). Specifically, nutmeg seed oil starting at concentrations of 150 to 500 mg/mL, along with nutmeg leaf oil at 500 mg/mL, demonstrated more pronounced inhibitory effects compared to the positive control.
Table 4 The effect of nutmeg oils on growth of Streptococcus mutans.
Treatments |
Diameter of inhibition zone (mm) by essential oils from- |
||
Seeds (x ± sd) |
Leaves (x ± sd) |
Mace (x ± sd) |
|
Positive control |
8.45 ± 7.41 |
12.29 ± 0.33 |
12.65 ± 0.55 |
EO 500 mg/mL |
12.25 ± 0.94a |
12.81 ± 0.65a |
10.85 ± 2.43a |
EO 250 mg/mL |
11.14 ± 1.49a |
10.30 ± 1.27ab |
8.98 ± 0.82ab |
EO 150 mg/mL |
8.87 ± 0.67ab |
10.44 ± 1.78a |
8.38 ± 0.52ab |
EO 77 mg/mL |
5.22 ± 4.53b |
8.15 ± 0.94ab |
7.69 ± 0.19ab |
This study demonstrated that at a concentration of 150 mg/mL, nutmeg seed oil effectively suppressed S. mutans proliferation slightly exceeding that of antibiotics. Thus, using conventional antibiotics to control S. mutans has proven insufficient to completely prevent S. mutans growth, as evidenced by bacterial proliferation within the clear zone. Antibiotic resistance may develop through enzymatic inactivation of drugs, reduced antibiotic influx into bacterial cells, or genetic mutations that lower the drug’s effectiveness at its target sites [26]. These results indicate that nutmeg essential oil could be a promising alternative for controlling S. mutans, offering effective bacterial control while potentially minimizing the emergence of antibiotic resistance.
Table 5 The effect of nutmeg oils on growth of Staphylococcus aureus.
Treatments |
Diameter of inhibition zone (mm) by oils from- |
||
Seeds (x ± sd) |
Leaves (x ± sd) |
Mace (x ± sd) |
|
Positive control |
30.36 ± 4.23 |
33.95 ± 1.30 |
32.83 ± 2.28 |
EO 500 mg/mL |
8.10 ± 0.28ab |
10.72 ± 1.80a |
10.68 ± 1.36a |
EO 250 mg/mL |
8.58 ± 0.53ab |
9.73 ± 1.79ab |
10.42 ± 1.14a |
EO 150 mg/mL |
5.47 ± 2.74b |
8.48 ± 0.38ab |
8.17 ± 0.37ab |
EO 77 mg/mL |
7.95 ± 0.47ab |
8.36 ± 0.44ab |
7.48 ± 0.18ab |
Means ± SD (n = 3). Different letters within column/row indicate significant differences at p < 0.0.5 (Tukey’s HSD).
Table 5 indicated various concentration of nutmeg oil had no discrenible effect on the inhibition of S. aureus. Nonetheless, in vitro results indicted that both of leaf and mace oils exhibited greater inhibitory efficacy against S. aureus compare to seed oil. These results align with the previous report that nutmeg seed oil in nano-formulation, at concentrations of 100%, 75%, 50%, and 25%, exhibited the weakest inihibitory against S. aureus at all concentration, although this formulation can inhibit bacterial biofilm formation [27]. Previous study found that mace oil was more effective than nutmeg seed oil in inhibiting S. aureus. According to their study, the antibacterial activity of plant extracts is largely attributed to phenolic compounds, which can damage bacterial cell walls and membranes, penetrate the cytoplasmic membrane, enter cells, and disrupt cellular metabolism [28].
Similar to previous experiments, mace oil at concentrations of 250 and 500 mg/mL proved to be more effective than both of nutmeg leaf and seed oil in inhibiting the growth of C. albicans. The findings of this study reveal that nutmeg oil at a concentration of 77 mg/mL is capable of inhibiting the growth of various pathogens, although its effectiveness remains lower than that of antibiotics. This inhibitory effect is believed to be primarily influenced by the presence of major active components rather than minor ones. Several bioactive compounds found in nutmeg oil are known to play a role in the fixation or binding process to bacterial cell walls and membranes, ultimately disrupting their integrity and function, which in turn hinders vital microbial cellular activities.
Table 6 The effect of nutmeg oils on growth of Candida albicans.
Treatments |
Diameter of inhibition zone (mm) by oils from- |
||
Seeds (x ± sd) |
Leaves (x ± sd) |
Mace (x ± sd) |
|
Positive control |
24.91 ± 0.71 |
25.53 ± 2.25 |
27.67 ± 0.46 |
EO 500 mg/mL |
12.23 ± 0.75ab |
11.48 ± 0.79abc |
15.32 ± 0.50a |
EO 250 mg/mL |
9.69 ± 0.16bc |
9.33 ± 0.25bc |
10.81 ± 0.37abc |
EO 150 mg/mL |
6.46 ± 5.61c |
8.84 ± 1.06bc |
9.10 ± 0.64bc |
EO 77 mg/mL |
8.71 ± 0.50bc |
8.66 ± 0.32bc |
8.54 ± 0.31bc |
Means ± SD (n = 3). Different letters within column/row indicate significant differences at p < 0.0.5 (Tukey’s HSD).
Effect of nutmeg oil on microbial growth rate in vitro
Nutmeg oil has demonstrated an ability to inhibit the growth of microorganisms associated with the oral cavity. At a concentration of 10%, oils extracted from nutmeg seeds, leaves, and mace significantly reduced pathogen populations. This reduction was reflected in lower absorbance readings, which serve as an indirect measure of microbial density. As noted by Beal et al. [29] the most widely used method for estimating cell numbers in a liquid suspension is through optical density (OD) measurements at 600 nm. However, the correlation between OD values and actual cell counts (cells/mL) is complex and influenced by multiple factors, including the light path length, particle size, and particle concentration in the suspension.
The impact of essential oil application on bacterial growth dynamics is illustrated in Figure 2. The data indicate that S. mutans, S. sanguinis, and S. aureus have higher intrinsic growth rates compared to C. albicans. Following the application of nutmeg oil, microbial populations in all treatment groups exhibited a marked decline within the first 4 h and continued to decrease steadily up to 24 h. In contrast, the control groups - untreated with nutmeg oil - displayed a consistent increase in population from the 6th h onward, reaching their highest densities by the 24th h of incubation.
This pronounced and sustained reduction in microbial populations underscores the potential of nutmeg oil as an early-stage antimicrobial intervention for oral pathogens. By rapidly lowering bacterial counts, nutmeg oil disrupts the critical period during which pathogens attempt to establish themselves in the oral environment. Importantly, it effectively prevents oral bacteria from entering the logarithmic (exponential) growth phase, thereby limiting their ability to colonize, spread, and form biofilms that are more resistant to treatment.

Figure 2 The effect of nutmeg oil application on suppressing microbial growth (A: S. mutans, B: S. sanguinis, C: S. aureus, D: C. albicans).
Nutmeg oil demonstrates notable antimicrobial potential, effectively suppressing the growth of key oral pathogens within a relatively short time frame. The inhibitory activity against S. mutans and S. aureus was evident as early as 4 h after application and persisted for the full 24-hour observation period. For S. sanguinis and C. albicans, growth inhibition became apparent after 6 h of treatment. Interestingly, nutmeg oil exhibited exceptional efficacy against C. albicans, a slow-growing fungal pathogen, whereas untreated controls experienced continuous pathogen proliferation from 2 to 24 h after incubation.
The rapid onset of antimicrobial activity - occurring within 4 to 6 h - supports the potential of nutmeg oil as a safe and effective natural alternative for oral infection management. This early suppression is especially significant for preventing pathogen establishment, as it interrupts the critical initial colonization period. Quantitatively, after 24 h of treatment, C. albicans growth was reduced by 79.13% with nutmeg leaf oil, making it the most potent antifungal among the tested oils. In contrast, the same oil inhibited S. mutans growth by only 34.18%. Nutmeg seed oil proved most effective against S. mutans, although its inhibitory effect diminished over time.
Oils from leaves and mace appear to be more effective against slower-growing pathogens such as S. aureus and C. albicans, likely due to higher content of oxygenated terpenes and phenolic compounds, including terpinen-4-ol, safrole, and eugenol which are less volatile. These compounds maintained inhibitory concentrations for extended periods, allowing effective suppression of slower-growing pathogens. The observation was consistent with previous reports highlighting the importance of oxygenated terpenes and phenolics in antimicrobial activity. Nutmeg seed oil, on the other hand, which is rich in volatile monoterpene hydrocarbons rapidly releases its active compounds, allowing for immediate suppression of fast-growing microbes [30,31].
Overall, the inhibition rates for S. aureus and S. sanguinis ranged from 47.49% - 60.99% and 47.89% - 74.09%, respectively, with nutmeg leaf oil achieving the highest suppression values. Nutmeg seed and mace oils demonstrated comparable efficacy, consistent with results from the disc diffusion assay. These findings confirm that nutmeg oil can significantly reduce oral pathogen populations, and by disrupting quorum sensing, it may also decrease pathogen virulence and the likelihood of biofilm formation [32].
Effect of nutmeg oils on pathogen cell morphology and aggregation
Scanning electron microscopy (SEM) revealed substantial morphological alterations in oral cavity microbial cells and cell aggregates following nutmeg oil treatment (Figure 3). Several mechanisms have been proposed to explain the antimicrobial activity of phytochemicals, including disruption of electron transport, dissipation of proton motive force, coagulation of the cytoplasmic membrane, and impairment of active transport processes [11,15,33]. In the present study, nutmeg oil application resulted in the disintegration of microbial colonies, producing less compact and more dispersed cell arrangements. Structural damage was observed particularly in S. mutans, S. sanguinis, and S. aureus. When nutmeg oil was applied at the initial growth stage of S. mutans, abnormal cell morphology was evident across all observed cells. In contrast, colonies of C. albicans exposed to nutmeg oil retained greater structural integrity. Damage to microbial cells led to the disaggregation of colonies into single cells, indicating that early application of nutmeg oil is capable of inducing severe cellular disruption.
Morphological observations (Figure 4) revealed that exposure to nutmeg oil induced marked structural alterations in bacterial cells, characterized by a porous and wrinkled appearance, accompanied by cytoplasmic leakage through compromised cell walls. This structural damage is likely attributable to the action of key bioactive constituents of nutmeg, such as trimyristin, myristic acid, and myristicin, on bacterial cell wall integrity. The degradation of cell wall weakens intercellular adhesion, resulting in the formation of unstable aggregates [15,33].

Figure 3 Changes in cell aggregation patterns of oral cavity microorganisms following exposure to nutmeg oils.
In the untreated control, S. mutans cells maintained an intact morphology and remained clustered. However, after 8 h of incubation with nutmeg leaf oil, most S. mutans cells exhibited membrane lysis and separation of structural components. This indicates that nutmeg oil disrupts cell integrity by damaging the polysaccharide matrix. The dispersion of individual cells is consistent with a reduction in the polysaccharide matrix, which would otherwise facilitate aggregation [3]. The matrix, primarily composed of glucans, contributing to the bulk and structural stability of dental biofilms [3,7].
Similar patterns of cellular destruction were observed in S. sanguinis, characterized by membrane cracks and leakage. The loss of intracellular contents resulted in cell shrinkage, wrinkling, and eventual cell death. In S. aureus, treatment with nutmeg oil caused marked surface roughness and numerous creases, indicative of cell wall damage, in contrast to the untreated control cells, which retained a smooth, spherical morphology. Following exposure to nutmeg essential oil, S. aureus cell morphology shifted, with early damage evidenced by depressions in the peptidoglycan layer. After 8 h of exposure, the cells became wrinkled and distorted, consistent with cytoplasmic leakage. Extensive damage to the peptidoglycan layer and cell membrane led to significant cell death and detachment from the filter substrate, resulting in a reduced number of identifiable bacterial cells in treated samples. The observed decrease in cell diameter, size, and length in S. aureus likely reflects the leakage of cytosolic fluid induced by the active compounds present in the oil.

Figure 4 Morphological cell of oral cavity microbes following exposure to nutmeg oils
In contrast, untreated C. albicans cells maintained normal growth with a smooth surface and intact cell-to-cell adhesion, consistent with typical budding patterns during cell division. Bud formation from mother cells occurred normally, supporting sustained population growth. However, nutmeg oil exposure altered both the morphology and architecture of C. albicans cells. The cell membrane became lysed and damaged, producing a furrowed surface. Moreover, budding was absent, leading to a substantially reduced cell population. Lysis of parent cells disrupted the growth of newly formed cells, resulting in morphological abnormalities. This type of structural damage is analogous to the effects of amphotericin B on C. albicans, where both mother and daughter cells are compromised [34]. The active components of essential nutmeg oil, such as myristicin, myristic acid, trimyristin, elemicin, and safrole, have good antimicrobial activity and are effective against endodontic microorganisms [35]. Finally, nutmeg oil as a natural antimicrobial may reduce systemic toxicity and bacterial resistance induced by synthetic antibacterial medications.
Conclusions
This study aimed to compare the antimicrobial efficacy of leaf, seed, and mace nutmeg oils against oral microorganism. Our results demonstrate that leaf and mace oils, rich in oxygenated terpenes and phenolics, are more effective against slower-growing microbes, while seed oil, containing volatile monoterpene hydrocarbons, rapidly suppresses fast-growing pathogens. These findings provide insight into how chemical composition influences antimicrobial activity.
The microbial populations decreased after 4 h of application, with cell disintegration, structural abnormalities, and weakened intercellular bonds observed under treatment. These observations highlight the potential of nutmeg oils as natural antimicrobial agents. Limitations include the in vitro nature of the assays, indicating the need for in vivo studies. Future research should explore synergistic effects of oil constituents and validate their efficacy in clinical settings.
Acknowledgements
The authors would like to thank the Ministry of Education and Culture, Research and Technology which has funded this research through the Doctoral Dissertation Research Grant and LPPM IPB University, Indonesia which has facilitated the implementation of the research.
Declaration of generative AI in scientific writing
The authors acknowledge the use of generative AI tools (QuillBot and ChatGPT by OpenAI) in the preparation of this manuscript, specifically for language editing and grammar correction. No content generation or data interpretation was performed by AI. The authors take full responsibility for the content and conclusions of this work.
CRediT author statement
Renny Utami Somantri: Methodology, Investigation, Writing - Review & Editing; Sugiarto: Supervision, Methodology, Visualization; Khaswar Syamsu: Supervision, Funding acquisition, Resources; Titi Candra Sunarti: Conceptualization, Supervision, Funding acquisition; Evi Savitri Iriani: Supervision, Validation; Syahri: Investigation, Writing-Original draft.
References
[1] JR Willis, E Saus, S Iraola-Guzmán, E Ksiezopolska, L Cozzuto, LA Bejarano, N Andreu-Somavilla, M Alloza-Trabado, A Blanco, A Puig-Sola, E Broglio, C Carolis, J Ponomarenko, J Hecht and T Gabaldón. Citizen-science reveals changes in the oral microbiome in Spain through age and lifestyle factors. npj Biofilms Microbiomes 2022; 8(38), 1-11.
[2] JS Zhang, CH Chu and OY Yu. Oral microbiome and dental caries development. Dentistry Journal 2022; 10(10), 184.
[3] D Ye, Y Liu, J Li, J Zhou, J Cao, Y Wu, X Wang, Y Fang, X Ye, J Zou and Q Ma. Competitive dynamics and balance between Streptococcus mutans and commensal streptococci in oral microecology. Critical Reviews in Microbiology 2025; 51(3), 532-554.
[4] S Hopkins, S Gajagowni, Y Qadeer, Z Wang, SS Virani, JH Meurman and C Krittanawong. Oral health and cardiovascular disease. The American Journal of Medicine 2024; 137(4), 304-307.
[5] FM Georges, NT Do and D Seleem. Oral dysbiosis and systemic diseases. Frontiers in Dental Medicine 2022; 3, 995423.
[6] O Koren, A Spor, J Felin, F Fåk, J Stombaugh, V Tremaroli, CJ Behre, R Knight, B Fagerberg, RE Ley and F Bäckhed. Human oral, gut, and plaque microbiota in patients with atherosclerosis. Proceedings of the National Academy of Sciences 2011; 108, 4592-4598.
[7] HE Kim, Y Liu, A Dhall, M Bawazir, H Koo and G Hwang. Synergism of Streptococcus mutans and Candida albicans reinforces biofilm maturation and acidogenicity in saliva: An in vitro study. Frontiers in Cellular and Infection Microbiology 2021; 10, 623980.
[8] J Campos, MF Pires, M Sousa, C Campos, CFFA da Costa and B Sampaio-Maia. Unveiling the relevance of the oral cavity as a Staphylococcus aureus colonization site and potential source of antimicrobial resistance. Pathogens 2023; 12(6), 765.
[9] JP Lopes and MS Lionakis. Pathogenesis and virulence of Candida albicans. Virulence 2022; 13(1), 89-121.
[10] MA Lugo-Flores, KP Quintero-Cabello, P Palafox-Rivera, BA Silva-Espinoza, MR Cruz-Valenzuela, LA Ortega-Ramirez, GA Gonzalez-Aguilar and JF Ayala-Zavala. Plant-derived substances with antibacterial, antioxidant, and flavoring potential to formulate oral health care products. Biomedicines 2021; 9(11), 1669.
[11] MF Warsito. A review on chemical composition, bioactivity, and toxicity of Myristica fragrans Houtt. essential oil. Indonesian Journal of Pharmacy/Majalah Farmasi Indonesia 2021; 32(3), 304-313.
[12] MU Din, A Ali, M Yasir, MI Jilani, S Shoaib, M Latif, A Ahmad, S Naz, F Aslam, M Iqbal and A Nazir. Chemical composition and in vitro evaluation of cytotoxicity, antioxidant and antimicrobial activities of essential oil extracted from Myristica fragrans Houtt. Polish Journal of Environmental Studies 2021; 30(2), 1585-1590.
[13] M Chakraborty, T Afrin and SK Munshi. Microbiological quality and antimicrobial potential of extracts of different spices. Food Research 2020; 4(2), 375-379.
[14] B Ginting, Mustanir, Nurdin, Maulidna, Murniana and Safrina. Evaluation of antioxidant and anticancer activity of Myristica fragrans Houtt. bark. Pharmacognosy Journal 2021; 13(3), 780-786.
[15] Z Shafi, VK Pandey, U Habiba, R Singh, M Shahid, S Rustagi, B Kovács and AM Shaikh. Exploring the food safety and preservation landscape of Myristica fragrans (L.) against foodborne pathogen: A review of current knowledge, Journal of Agriculture and Food Research 2025; 19, 101639.
[16] MT Ha, NK Vu, TH Tran, JA Kim, MH Woo and BS Min. Phytochemical and pharmacological properties of Myristica fragrans Houtt.: an updated review. Archives of Pharmacal Research 2020; 43(11), 1067-1092.
[17] JK Dzotam and V Kuete. Myristica fragrans as a potential source of antibacterial agents. In Advances in Botanical Research 2023; 107, 213-237.
[18] K Ashokkumar, J Simal-Gandara, M Murugan, MK Dhanya and A Pandian. Nutmeg (Myristica fragrans Houtt.) essential oil: A review on its composition, biological, and pharmacological activities. Phytotherapy Research 2022; 36(7), 2839-2851.
[19] V Nikolic, L Nikolic, A Dinic, I Gajic, M Urosevic, L Stanojevic, J Stanojevic and B Danilovic. Chemical composition, antioxidant and antimicrobial activity of nutmeg (Myristica fragrans Houtt.) seed essential oil. Journal of Essential Oil Bearing Plants 2021; 24(2), 218-227.
[20] M Ramli, MAR Nor-Khaizura, ZAN Hanani, Y Rukayadi and NIP Samsudin. Potential application of bioactive compounds in essential oils from selected Malaysian herbs and spices as antifungal agents in food systems. Food Research 2021; 5(4), 223-237.
[21] B Shan, YZ Cai, JD Brooks and H Corke. The in vitro antibacterial activity of dietary spice and medicinal herb extracts. International Journal of Food Microbiology 2007; 117(1), 112-119.
[22] A Trifan, G Zengin, I Korona-Glowniak, K Skalicka-Woźniak and SV Luca. Essential oils and sustainability: In vitro bioactivity screening of Myristica fragrans Houtt. post-distillation by-products. Plants 2023; 12(9), 1741.
[23] AS Buru, VK Neela, K Mohandas and MR Pichika. Microarray analysis of the genomic effect of eugenol on Methicillin-Resistant Staphylococcus aureus. Molecules 2022; 27(10), 3249.
[24] M Ulanowska and B Olas. Biological properties and prospects for the application of eugenol - a review. International Journal of Molecular Sciences 2021; 22(7), 3671.
[25] K Ramírez-Alarcón, M Martorell, ES Gürer, I Laher, HL Lam, EAM Mohieldin, AM Muddathir, M Akram, M Iqbal, H Shafique, G Leyva-Gómez, S Shaheen, M Kumar, J Sharifi-Rad, R Amarowicz and M Butnariu. Myristicin: From its biological effects in traditional medicine in plants to preclinical studies and use as ecological remedy in plant protection. eFood 2023; 4(3), e90.
[26] T Oo, B Saiboonjan, S Srijampa, A Srisrattakarn, K Sutthanut, R Tavichakorntrakool, A Chanawong, A Lulitanond and P Tippayawat. Essential oil from Myristica fragrans Houtt. (nutmeg) seeds. Molecules 2021; 26(15), 4662.
[27] SM Hadi, AM Etheb, AH Omran and SH Hassan. Characterization, biofilm and plasmid curing effect of silver nanoparticles synthesis by aqueous extract of Myristica fragrans seeds. Jordan Journal of Biological Sciences 2022; 15(1), 149-158.
[28] W Kusalaruk and H Nakano. Hurdle effects of ethanolic plant extracts with antimicrobials commonly used in food against foodborne pathogenic Escherichia coli. Microbiology Research 2021; 12(2), 288-298.
[29] J Beal, NG Farny, T Haddock-Angelli, V Selvarajah, GS Baldwin, R Buckley-Taylor, M Gershater, D Kiga, J Marken, V Sanchania, A Sison and CT Workman. Robust estimation of bacterial cell count from optical density, communications Biology 2020; 3, 512.
[30] M Hyldgaard, T Mygind and RL Meyer. Essential oils in food preservation: Mode of action, synergies, and interactions with food matrix components. Frontiers in Microbiology 2012; 3, 12.
[31] S Chouhan, K Sharma and S Guleria. Antimicrobial activity of some essential oils - present status and future perspectives. Medicines 2017; 4(3), 58.
[32] PP Wright and SS Ramachandra. Quorum sensing and quorum quenching with a focus on cariogenic and periodontopathic oral biofilms. Microorganisms 2022; 10(9), 1783.
[33] A Maurya, J Prasad, S Das and AK Dwivedy. Essential oils and their application in food safety. Frontiers in Sustainable Food Systems 2021; 5, 653420.
[34] E Grela, A Zdybicka-Barabas, B Pawlikowska-Pawlega, M Cytrynska, M Wlodarczyk, W Grudzinski, R Luchowski and WI Gruszecki. Modes of the antibiotic activity of amphotericin B against Candida albicans. Scientific Reports 2019; 9(1), 17029.
[35] JV Setty, I Srinivasan, RT Sathiesh, M Kale, V Shetty and S Venkatesh. In vitro evaluation of antimicrobial effect of Myristica fragrans on common endodontic pathogens. Journal of Indian Society of Pedodontics and Preventive Dentistry 2020; 38(2), 145-151.